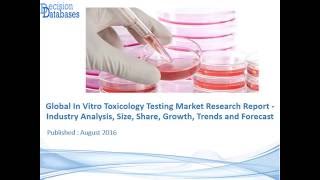

In Vitro Toxicology Testing Market Research Report Upto 2022 video
Online izle ve mp4 mp3 formatlarinda yukle
Videonun muddeti: 0:27
In Vitro Toxicology Testing Market Research Report Upto 2022 videosu mp4 ve mp3 yuklemek ucun hazirdir
Diqqet! Siz Mp4 yukle ve ya Mp3 yukle duymesine basdiqdan sonra eger sistem sizi reklam sehifesine atarsa o zaman derhal geri qayidib emeliyyati tekrar edin ve faylin yuklemek ucun hazir olmasini gozleyin
Videodan Mp4 Yukle
Videodan Mp3 Yukle-1
Videodan Mp3 Yukle-2
Oxshar Axtarishlar
In Vitro Toxicology Testing Market Research Report Upto 2022
Global In Vitro Toxicology Testing Market || Report Sellers
New study on In Vitro Toxicology Market 2021 industry trends & forecast
In-Vitro Toxicology Testing Market Forecast to 2018
EIC James M. McKim on Applied In Vitro Toxicology
Global In Vitro Toxicology Toxicity Testing Market 2018
ImmunoSearch : Next-generation quantitative in vitro topical toxicology assays
In Vitro Toxicology Market
In Vitro Diagnostics Market Growth Outlook 2022-2030
Video Mp4 Mp3Azwap.Biz
Azwap.Biz 2021-2023